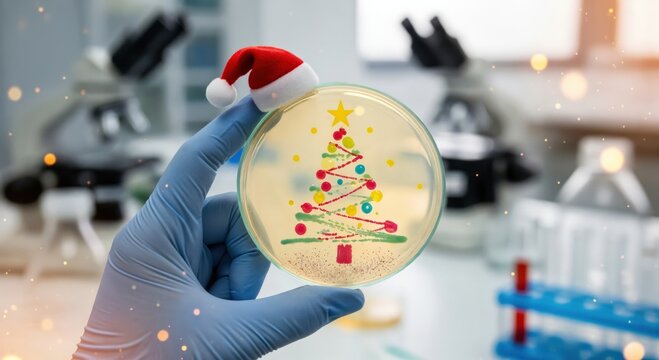
Scientist's gloved hand holding a petri dish with a festive Christmas tree made of colorful bacterial cultures in a laboratory, celebrating holiday science - Powered by Adobe

- Home >
- Stock Photos >
- Joyful Santa Claus with Dreadlocks Spreading Holiday Cheer
Joyful Santa Claus with Dreadlocks Spreading Holiday Cheer Image

AI Generated Image. Santa Claus with dreadlocks wearing classic red and white attire, laughing joyfully against a festive background with Christmas trees. Perfect for holiday greetings, Christmas promotions, or any seasonal celebrations highlighting traditions and joy.
0
downloads
downloads
Tags:
More
Credit Photo
If you would like to credit the Photo, here are some ways you can do so
Text Link
photo Link
<span class="text-link">
<span>
<a target="_blank" href=https://pikwizard.com/photo/joyful-santa-claus-with-dreadlocks-spreading-holiday-cheer/0a2e3223ce44bc99d1dc840cbeffd0fc/>PikWizard</a>
</span>
</span>
<span class="image-link">
<span
style="margin: 0 0 20px 0; display: inline-block; vertical-align: middle; width: 100%;"
>
<a
target="_blank"
href="https://pikwizard.com/photo/joyful-santa-claus-with-dreadlocks-spreading-holiday-cheer/0a2e3223ce44bc99d1dc840cbeffd0fc/"
style="text-decoration: none; font-size: 10px; margin: 0;"
>
<img src="https://pikwizard.com/pw/medium/0a2e3223ce44bc99d1dc840cbeffd0fc.jpg" style="margin: 0; width: 100%;" alt="" />
<p style="font-size: 12px; margin: 0;">PikWizard</p>
</a>
</span>
</span>
Free (free of charge)
Free for personal and commercial use.
Author: AI Creator
Similar Free Stock Images
Loading...